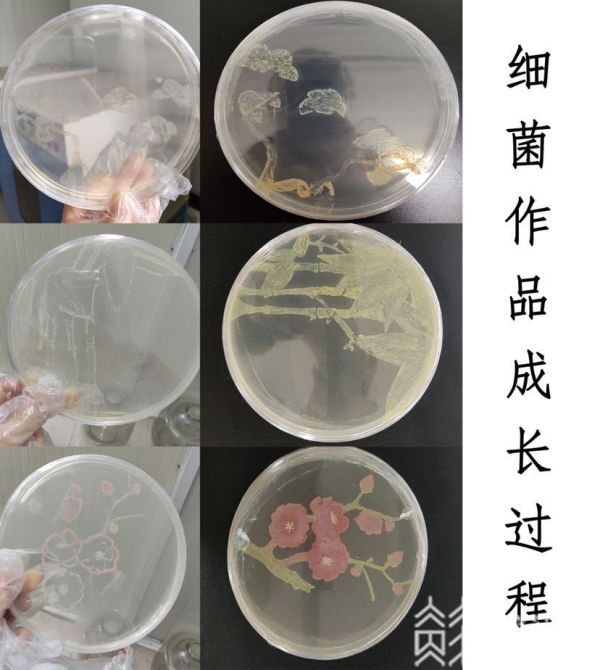

4月17日下午,由江苏省科协主办、省青少年科技中心承办的第七届全国青年科普创新实验暨作品大赛江苏赛区复赛在南京落下帷幕。本届比赛江苏首次作为独立赛区,共有13所高校、86所中学,近2400人参加初赛。风能利用比赛是本届大赛唯一的现场比赛类项目,面向中学生开展。共有来自34所学校的33支代表队现场制作借风力行驶的小车进行现场比赛。

风能利用比赛分三组平行赛道进行,比赛规定学生在90分钟里,两人一组,动手完成小车制作。过程中不能使用成品零件、轴承,以及成品风帆,只能使用大赛提供的重为200克的A4纸进行制作,其它零件可自带。选手通过不同构架和形状的小车,利用风能来完成比赛任务。
风能利用比赛裁判长徐自远告诉记者 :“我们有三台风扇放在地上,学生利用风能让自己的小车跑得又快又远,能够负越重的重量,他的成绩就越好,重量相同的情况下,我们选手制作的载具小车越轻他的名次就越靠前。这项比赛综合考察中学生多方面的能力,既有流体力学知识、机械结构设计能力,也考验创意及批判性思维、团队合作、沟通协调、自主学习、临场应变等能力。”

现场制作的小车大致分为两种,一种直接做成风帆型,通过调整角度让小车行驶,但普遍载重量不大,砝码载重基本上在2500克以内。江苏省赣榆中等专业学校二年级学生孙伟介绍说:“以45度的角度,直向吹着它,给它一种动力,前面两次的调试,在运动的过程中,后面的阻挡器变了方向,后期给它加固了一下,角度固定在45度了,就可以继续行走了。”

另外一种做成风车的形式,通过弱力驱动原理把弱力放大,载重量也随之增大,不少参赛选手把现场提供的所有砝码都放在了小车上,超出了原定承载量的最高4158克的预期。江苏省启东中等专业学校的郝董灿、李苏博告诉记者:“我们测试了(风帆)最大的承重量是3公斤,觉得不可取,就尝试用传动轴进行传动,用风力把这个风扇带动,其次就是线带动了下面的,相当于风力发动的一种吧。”
风能利用比赛裁判长徐自远说:“我们原来设计的过程中,给了3套砝码,三套砝码的基础上再准备了3个500克的砝码,本来我们认为4000多克的重量,已经是小车理论载重的极限了,没想到我们这次有好几组的选手都已经把我们所有的载重都加上,现在我看到好多选手都在锯自己的小车,在条件允许的情况下,尽可能地减轻重量,来获得好的成绩。”

本届全国青年科普创新实验暨作品大赛围绕“智能、安全、环保”三大主题,重点关注前沿科学技术及科学教育理念的应用与普及,共设四个赛题五个组别的比赛,分别是:智能控制(大学组、中学组)、未来教育(大学组)、生物环境(大学组)、风能利用(中学组)。

其中创意作品单元的智能控制、未来教育赛题旨在引导青年学生关注前沿科技,例如人工智能、机器人技术、电子信息技术等,发动智慧开发科技创新作品、科技馆展品、文创产品等;科普实验单元的生物环境和风能利用赛题考察青年学生对学科基本知识的了解以及科技实践操作的能力。
生物环境大学组一等奖“迎寒绽放,岁寒三友”连环画采用非遗文化、党史教育、廉政教育等元素结合现代科技赋予松、竹、梅新的生命。制作作品时团队在选“菌”上下功夫,从江苏省廉政教育基地平山堂的松、竹、梅植物中进行采集分离,其次运用非物质文化遗产中的剪纸元素刻画出松、竹、梅的形状,并且能更直观地把欧阳修、苏轼的廉政故事以作品的形式传递给更多青年学生。
扬州工业职业技术学院艺术设计学院学生杨威龙说:“红色也是从土壤里提取的,但是它是有一定几率,可能只有1%到2%的样子。操作杆是很细的钢丝,我们在勾画的时候很难把握它的稳定,我大概画了5组作品,15幅图,采取了其中3幅,我们在这个过程中发现,我们结合生物和艺术就是一个不同的收获。”

获得智能控制大学组一等奖的作品“爪刺式飞行爬壁机器人”,依靠微小爪刺的摩擦抓附实现机器人垂直壁面爬行功能,依靠四轴无人机实现机器人飞行功能。本项目通过理论分析和模拟计算,分别对机器人的各项结构进行设计,并完成对应的控制方法。团队负责人毛晨曦自行设计了爬壁系统、着陆系统和复飞系统,最终实现机器人的飞行,在粗糙壁面着陆和爬行,从粗糙壁面复飞的完整功能。
南京理工大学理学院力学与工程科学系研一学生毛晨曦说:“普通机器人的话器械专业可能做得更好,但是我们力学是把一些不可能实现的比如它的动作或者是它这种机械结构的设想,很多是要靠力学分析对它校核的。因为飞行的东西,会对它重量和稳定性要求更高。”

东南大学李佳昕团队“舌尖上的汉字”获得未来教育大学组一等奖,这是一款针对7到11岁具有初步认知力的儿童设计的汉字演变巧乐力3D打印机,通过打印巧乐力的方式吸引儿童在玩乐中学习中国汉字演变过程。东南大学艺术学院研一学生李佳昕告诉记者:“它把这种食品的打印机和汉字演变,这样一个文化进行结合,这是第一点的承载形式上,第二点就是人机交互方式上,儿童在书写汉字后可以选择哪个时期的汉字。”

颁奖仪式上,江苏省科协党组成员、副主席方胜昔表示,本届大赛在各级教育部门、各级科协、重点高校团委、新闻宣传部门的组织发动下,青年学子踊跃参与,科技创新作品脱颖而出,形成了以赛促学的良好氛围。科技教育工作需要社会各界的参与和支持,省科协将进一步搭建平台,与社会各界勠力同心,充分发挥科普活动培育创新土壤、营造创新环境的社会作用,为提高青少年科学素质、培养科技创新后备人才贡献力量。据悉,大赛各项第一名的优胜者将代表我省参加6月举行的全国决赛。
(来源:江苏广电融媒体新闻中心/黄迪 史哲铭 通讯员/黄奕涛 编辑/梁瑄)







公安备案号:32010202010067